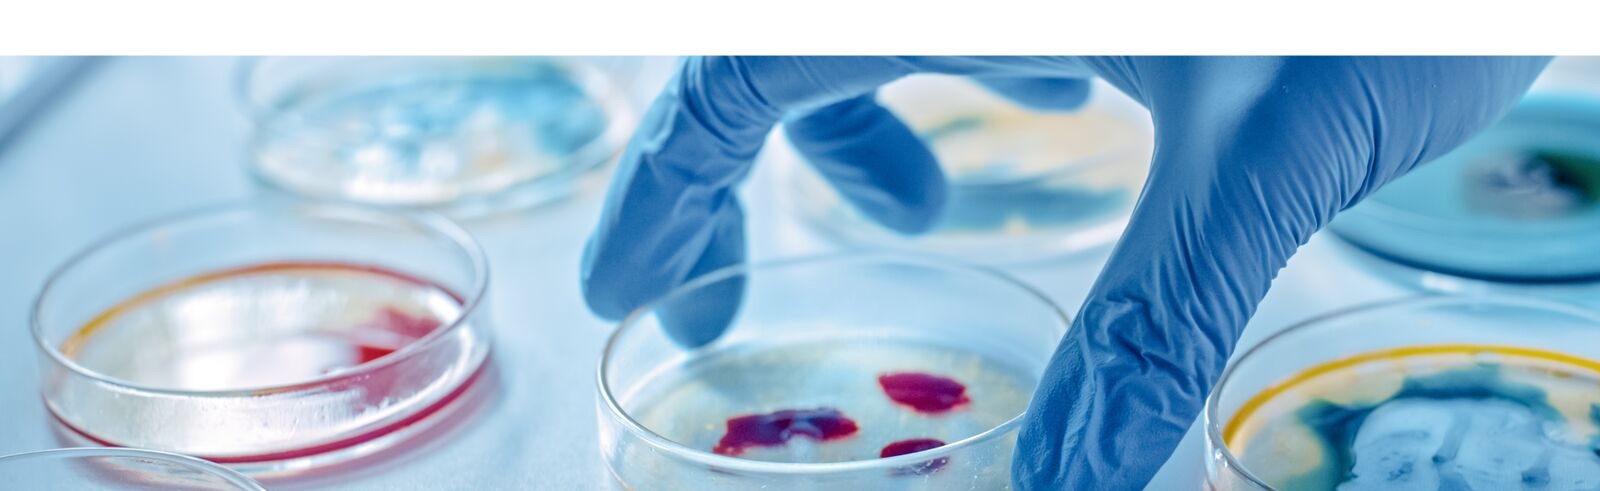

About us
GRIPE is an online seminar in International Political Economy. We invite faculty and graduate students with an interest in international political economy to sign up for our mailing list. We’ll use that list to distribute abstracts and schedules. We also will post the papers, the schedules, and the links to the recorded workshops here.
Please join the mailing list by joining the Google Group here.
Meetings are scheduled most weeks on Wednesdays at noon US eastern time. The Zoom address will be made available to participants ahead of each meeting.
If you have a paper you’d like to present, please let us know, at mepeters@ucla.edu.